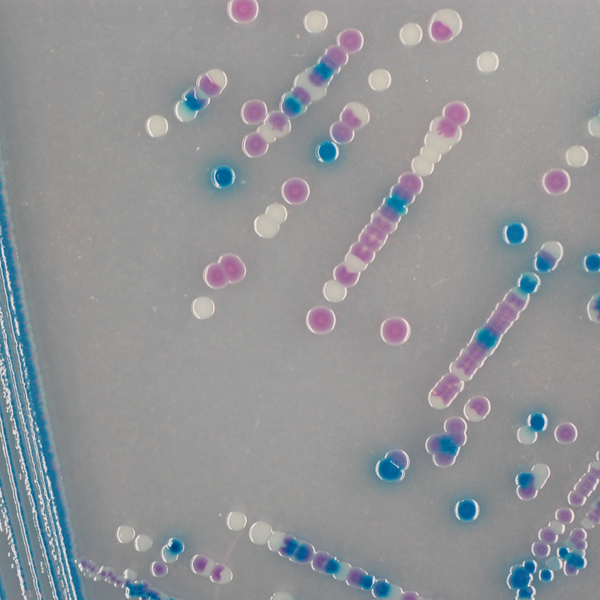
CHROMagar™ O157
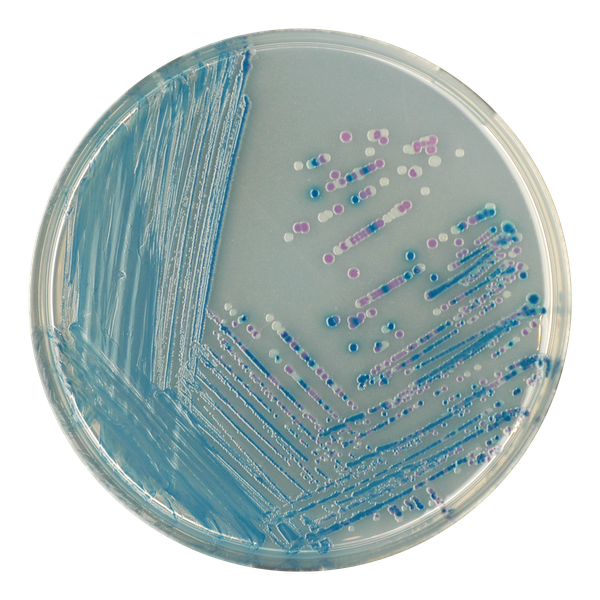
CHROMagar™ O157
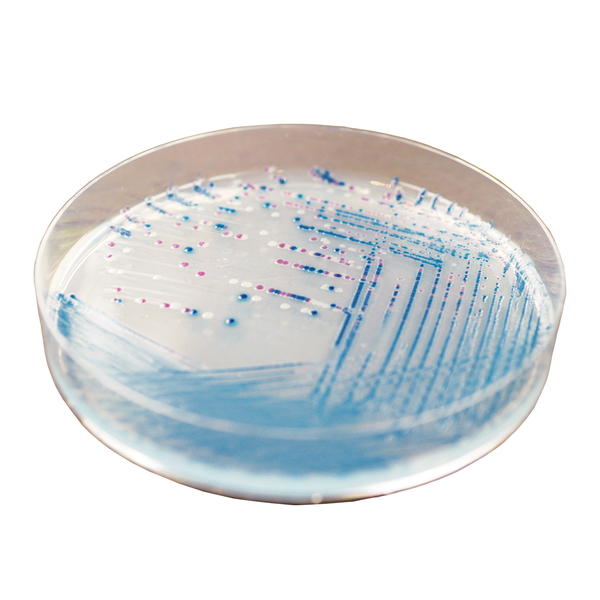
CHROMagar™ O157

Hình thái khuẩn lạc

E. coli O157
Màu tím nhạt

Các vi khuẩn khác
Màu xanh thép, không màu hoặc bị ức chế
Hiệu năng
Hiệu năng
Escherichia coli (E. coli) là vi khuẩn thường được tìm thấy trong đường ruột của con người và động vật máu nóng. Hầu hết các chủng E. coli đều vô hại. Tuy nhiên, một số chủng như E. coli tạo độc tố Verotoxin (VTEC), còn được gọi là E. coli tạo độc tố Shiga (STEC), có thể gây ra các bệnh do thực phẩm nghiêm trọng. E. coli gây xuất huyết tiêu hóa (EHEC) là một nhóm con của VTEC, có thể gây ra bệnh nặng ở người như hội chứng tan máu tăng urê (HUS). VTEC đã được phân lập từ nội dung ruột của nhiều loài động vật, bao gồm bò và cừu. VTEC chủ yếu lây nhiễm cho con người thông qua tiêu thụ thực phẩm bị ô nhiễm, nhưng cũng có thể lây qua việc xử lý động vật mang vi khuẩn này.
Serotype E. coli O157:H7 hoặc biến thể không di động O157:H- là serotype VTEC phổ biến nhất liên quan đến y tế công cộng. Sự quan trọng của nó đã được nhận ra vào năm 1982, sau hai đợt bùng phát ở Mỹ. Kể từ đó, hơn 180 đợt bùng phát đã được báo cáo trên toàn cầu, với con số ước tính của Tổ chức Y tế Thế giới là 70,000 ca nhiễm mỗi năm.
1. Dễ dàng phát hiện hơn so với SMAC: E. coli O157 được phát hiện qua màu tím hồng đặc trưng chỉ sau 24 giờ ủ, trong khi hầu hết E. coli khác có màu xanh. Môi trường truyền thống để phát hiện E. coli O157 là thạch Sorbitol MacConkey (SMAC), có độ đặc hiệu rất kém, do đó xuất hiện nhiều dương tính giả (như Proteus, E. hermanii, v.v.). Thạch Sorbitol MacConkey cũng khó đọc vì có sự thay đổi màu sắc trong trường hợp ủ lâu.
2. Độ nhạy cao: E. coli O157: 89% *
*Độ nhạy từ nghiên cứu khoa học: K.A. Bettelheim, 1998. Độ tin cậy của CHROMagar™ O157 để phát hiện E. coli gây xuất huyết tiêu hóa (EHEC) O157 nhưng không phải EHEC thuộc nhóm serotype khác. J. Appl. Microbiol. 85:425-428.
3. Tính linh hoạt:Đạt được sự linh hoạt khi sử dụng dạng bột thay vì đĩa sẵn sàng sử dụng.
.
Thành phần

Tài liệu kỹ thuật
Công bố khoa học
2012
Detection, isolation and molecular characterisation of Shigatoxigenic O157 and non-O157 Escherichia coli in raw and fermented camel milk
📄 Publication2007
Shiga-toxigenic Escherichia coli O157 and non-Shiga-toxigenic E. coli O157 respond differently to culture and isolation from naturally contaminated bovine faeces
📄 Publication2001
The optimization of isolation media used in immunomagnetic separation methods for the detection of Escherichia coli O157 in foods.
📄 Publication1998
Reliability of CHROMagar O157 for the detection of enterohaemorrhagic Escherichia coli (EHEC) O157 but not EHEC belonging to other serogroups
📄 Publication1996
The use of selective and differential agars in the isolation of Escherichia coli O157 from dairy herds
📄 Publication

Xem thêm